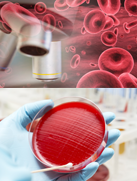
scanning and identification

automations role in regenerative medicine

Cellular therapies are on the verge of revolutionizing how patients are treated for some of the most chronic illnesses. Cell therapies offer regenerative abilities that are giving hope to both patients and their doctors. However, there is still much work to do in the laboratory. James Price, the president and chief executive of the Canadian Stem Cell Foundation, said, "Stem cell therapy will transform health care and how we treat devastating diseases. We are on the verge of breakthroughs that will fundamentally alter the treatment of illnesses such as diabetes, cancer, heart disease, and neurological diseases."
In their article, "Cell Based Therapeutics: The Next Pillar of Medicine", authors Fischbach, Bluestone, and Lin assert that Cell Therapies will become the Third Pillar of the drug industry alongside molecular and biochemistry.
Just imagine how serious something as insignificant as a paper cut could be were the body not able to coagulate the blood and stop the wound from bleeding out. Should pieces of modern industrial equipment spring a leak in a hydraulic line, there are provisions to shut down flow to that area of the machine, but certainly not to automatically repair the line without replacing it entirely. Think about how the body can react to a pathogen it has never seen before. The common cold or flu viruses mutate at a staggering rate, yet the body's immune system is still able to identify it as a foreign body and destroy it. While software has come a long way in defending your PC against computer viruses, it still needs to first be aware of them, hence requiring that you constantly update your PC to maintain its defense against the latest threats.
This whitepaper outlines Parker Hannifin Corporation's approach to partnering with researchers at the engineering and scientific levels, leveraging its precision motion and fluid handling expertise. This partnership will help researchers develop a device enabling qualification of stem/progenitor cells and automatic manipulation of key colonies of interest.
Analyzing cells with accuracy
The problem that many researchers in this field have faced is the inability to use large field of view (LFOV), high resolution optics to image cell cultures as a means of monitoring and quantifying cell-based changes. Additionally, the available devices lack the accuracy and precision required for rigorous sampling, transfer, or deletion of specific cells or colonies.
Today, most cell-based research and cell fabrication strategies are supported by manual processes. Colonies are often visually assessed and identified, counted or selected and manually transferred by a lab technician working under a microscope viewing a sample through a narrow field of view. Given the mundane and highly subjective nature of this method, results are highly inconsistent and subject to human error.
Quantitative methods for cell and colony metrics are typically limited to destructive assays, in which groups of cells are combined and analysis of the proteome or gene expression of the entire population is assessed. While these destructive methods provide accurate quantitative information, it only provides an average assessment of the cell colony type. An automated image-based system would allow for both accurate quantitative metrics of biological performance (cell size, number, morphology, surface markers, extracellular matrix properties, and — in some settings — gene expression or secretory profile). Moreover, these metrics can be applied on a cell-by-cell or colony-by-colony level, as well as at the level of gross population metrics.
In contrast, a manual colony count, the most common method for quantifying the number of stem cells or progenitors in a given sample, is highly variable. Manual counts of the same sample frequently differ by 100% between observers and within the same observer at different times. Furthermore, beyond just a number of colonies, manual counts fail to provide quantitative data on the features of each colony that was counted. Nor do such counts create a durable record of the status of each colony at the time of assay.
Despite the enormous progress and promise in the field of cell therapy development, unresolved challenges continue to plague the community exploring cell-based diagnostics. Here's how Dr. George Muschler of the Cleveland Clinic, and Cell X? innovator, characterizes these unresolved issues:
"A critical gap in current stem cell and progenitor cell biology that limits translation into effective therapies is our current inability to define and measure critical quality attributes (CQAs) in the stem cell and progenitor populations in our labs today. These attributes must be defined based on quantitative and standardized metrics. With this information we can then act, using appropriate tools, to rapidly identify and isolate desired cells or clones, or to delete undesired cells/clones from our clinical therapies and critical research studies."
Anatomy of a Cell X stem and progenitor cell handler
Cells are tiny living, breathing things; as such they must be handled with precision and care. Automated handling equipment in particular needs a heightened level of dexterity and control. When looking at typical therapy processes, there are effectively two major processes:
scanning and identification
1. Scanning and identification – Using optics, in conjunction with motion systems and control algorithms, to find cells or clusters of cells of interest and identify their location in 3D space.
2. Cell selection process – Positioning cells of interest and interactive surgical tools to selectively biopsy cells of interest, remove undesired cells, or transplant desired cells into a site where they can be further expanded, processed, or studied.
Parker has unique experience to aid in the development of these systems given the vast number of industries it has supported over the years. It has developed several different platform products that have been designed for manufacturability, modularity, and all importantly, performance. The scanning and identification process directly aligns with Parker's experience in digital pathology, enabling high precision, on-the-fly capture of high resolution images of cell biopsies. The cell selection process directly aligns with the company's experience in additive manufacturing, precisely placing material where it belongs.
In today's fast paced world of product development, typical development cycles have been reduced significantly. Innovators inevitably compete, both in biological discovery and in getting to market first with the most effective and efficient products and systems for manufacturing. Discovery, product optimization and systems for manufacturing are linked directly with the instruments needed to see and control these events.
Parker specializes in optimizing how highly engineered products plug and play with one another.
Engineering a solution
Sometimes Parker's customers require further customization of standard products to meet application requirements. For example, it has worked with Dr. Muschler and his team spanning several major medical institutions to develop the Cell X? Device. Cell X combines large field of view imaging with precision instrumentation, fluidics, and documentation and control LFOV capabilities. Cell X opens new dimensions of opportunity for discovery and development of stem cell therapeutics. These same features also provide new avenues for quantitative personalized cell-based diagnostics, optimization of biomaterials and bioactive surface design, and drug discovery applications.
The central core of the device is a high quality automated inverted microscope and CCD camera, with both brightfield and fluorescent imaging options.
Engineering a Solution
Why is Parker the right partner?
The future of cell therapy development is having quantitative and reproducible standards that enable the determination and management of critical quality attributes for cells and colonies, thus providing optimal safety and efficacy. To address this critical challenge, Parker is partnering to make important contributions to the tools available.
Selecting the right partners is key to developing new tools and instruments. Parker has a proven track record of aiding original equipment manufacturers (OEMs), and using our engineering expertise to accelerate development cycles and increase project success.
We look forward to the future of cell therapies and associated advances in healthcare, and hope that our automated systems will play a key role in transforming biological understanding and in making these therapies available affordably to improve all lives.
Valin Corporation is an authorized distributor of Parker and partners with Parker to give our customers the best possible solution.
1 http://ottawacitizen.com/news/national/stem-cell-advocates-therapy-launch-10-year-1-5b-action-plan
2 http://stm.sciencemag.org/content/5/179/179ps7.full